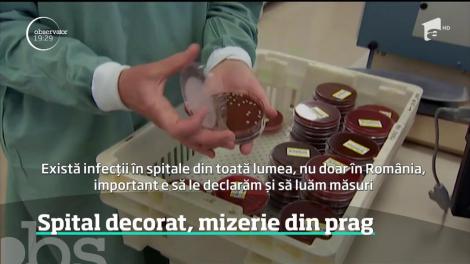
Pacienți uciși de bacterii, la spitalul din Drobeta Turnu Severin

Articole despre bacterii

Șaorma cu bacterii periculoase pe litoral. Mâncarea de la mare, testată în Campania Observator Antena 1 „Ce ne puneți în mâncare”
Observator a dus la control mâncărurile preferate ale turiştilor de pe litoralul românesc în cel mai recent episod al Campaniei „Ce ne puneți în mâncare”.
Miercuri, 13.08.2025, 16:37
Cum trebuie să speli șosetele corect. Experții au dezvăluit greșeala pe care o fac mulți după ce le scot din mașina de spălat
Experții au dezvăluit cum trebuie să speli șosetele corect și ce trebuie să faci după ce le scoți din mașina de spălat.
Sambata, 09.08.2025, 09:00
Obiectul care ar fi de 40 de ori mai murdar decât un capac de toaletă. E folosit de milioane de persoane
Experții au dezvăluit obiectul care ar fi de 40 de ori mai murdar decât un capac de toaletă, care e folosit de milioane de persoane, uneori zilnic.
Sambata, 19.07.2025, 09:00
Pericolul ascuns din cuptorul cu microunde. Incredibil câte bacterii se găsesc în interior și cum ne afectează sănătatea
Un studiu spaniol sugerează că printre bacteriile din cuptorul cu microunde se află inclusiv unele care pot cauza toxiinfecții alimentare. Numărul estimat? Peste 100 de tipuri periculoase pentru sănătatea umană.
Sambata, 19.04.2025, 17:30
Mănușile, un risc pentru sănătatea ta. De ce nu este bine să le porți des iarna
Mănușile sunt accesoriul aproape nelipsit din garderoba românilor pe timp de iarnă. Iată de ce nu sunt recomandate.
Luni, 24.02.2025, 16:38
Ce locuri de la birou trebuie să cureți neapărat!Majoritatea persoanelor trec cu vederea peste zonele pline de microbi și bacterii
Există câteva locuri la birou la care nu te-ai fi gândit niciodată că pot fi pline de bacterii. Cu toate acestea, experții au dezvăluit ce zone și ce obiecte ar trebui să curățam mult mai des decât de obicei.
Vineri, 05.04.2024, 13:57
Ce bacterii se găsesc pe tacâmurile de la restaurant. Mulți au fost surprinși să afle numărul lor
Multe persoane preferă să mănânce în oraș, dar puține știu ce bacterii se găsesc pe tacâmurile primite la restaurant. Iată ce a descoperit un expert și ce spun studiile.
Joi, 22.02.2024, 17:49
De ce este bine sau nu ca orezul să fie spălat înainte de gătit. Obiceiul care ar putea salva vieți
Pe scurt, da. Dar motivul nu este cel la care te-ai fi așteptat.
Marti, 19.09.2023, 12:44
Ce spune Rafila despre persistența bacteriilor și virusurilor în pereții clădirilor: "Problema este la nivelul instalaţiilor"
Pornind de la situația că sunt anumite voci în spațiul public susţin că unele spitale vechi ar trebui să fie demolate și nicidecum transformate în clădiri de locuit, ministrul Sănătății Alexandru Rafila, a adus clarificări în emisiunea Prima News. Medicul afirmă că este falsă ideea conform căreia imobilele în care funcţionează spitale vechi ar trebui demolate. El explică faptul că bacteriile şi virusurile nu persistă în ziduri sau pereți, ci în instalaţiile sanitare ale clădirilor.
Marti, 06.12.2022, 15:07
Medicool sezonul 3, 1 octombrie 2022. Cum ne influențează viața bacteriile
Episodul 6 de la MediCOOL - Sezonul 3, din 1 octombrie 2022. Doctorul Mihail Pautov ne spune cum ne influențează viața bacteriile. În primul rând, trebuie să fim , cu toții, conștienți de faptul că avem trilioane de bacterii pe corpul nostru...

Tardigradele, cele mai rezistente creaturi din lume. Ce sunt și de ce spun specialiștii că nu pot fi distruse
E greu de crezut că există ființe extrem de rezistente, care reușesc să supraviețuiască chiar și în cele mai vitrege medii, dar oamenii de știință au demonstrat că e posibil.
Vineri, 16.10.2020, 15:46
Spală-te pe mâini imediat după ce atingi următoarele 10 obiecte. Sunt pline de germeni
În special în această perioadă, cu toții am învățat despre importanța spălatului pe mâini și cât de mult e poate proteja de eventualele boli.
Vineri, 18.09.2020, 11:13
Banii românești pot fi purtători de Covid-19 pentru că sunt din plastic: "Sunt cei mai murdari din lume și transmit cele mai rezistente virusuri"
Bancnotele din plastic pot transmite coronavirusul! Leii româneşti transmit cele mai rezistente bacterii, arată un studiu realizat de doi cercetători străini. Specialiştii spun că materialul din care sunt făcuţi îi face greu de replicat, dar şi magnet pentru bacterii extrem de periculoase, precum Covid-19.
Marti, 10.03.2020, 17:35
Nouă armă mortală pentru viruși și bacterii
De acum, microbii de pe calculatoare şi alte obiecte de birou pot fi eliminaţi mai eficient cu o armă ce pare desprinsă din filmele SF Este, de fapt, un pulverizator special cu ajutorul căruia substanţa dezinfectantă aderă perfect la suprafaţa...
Sambata, 28.12.2019, 09:18
Așa cureți corect bucătăria! Află acum cele mai eficiente metode prin care scapi 100% de bacterii
Cu siguranță obiectele și suprafețele din bucătărie sunt cele care se murdăresc cel mai ușor, comparativ cu celelalte camere din locuințele noastre.
Joi, 24.10.2019, 23:39
Gheaţă cu bacterii periculoase în marile lanţuri de fast-food din România. Medici: "Pot provoca enterocolite și alte boli grave"
Gheaţă produsă fără avize şi contaminată cu bacterii periculoase. Asta au găsit comisarii ANPC la un singur restaurant fast-food al uneia dintre cele mai cunoscute companii din întreaga lume. Gheaţa plină de germeni ajungea în paharele cu băuturi răcoritoare ale clienţilor.
Marti, 22.10.2019, 21:40
Gheaţă cu bacterii periculoase şi germeni sau produse fără avize. Asta au găsit inspectorii ANPC în urma unui control la cele mai mari lanţuri de fast-food
Gheaţă produsă fără avize şi contaminată cu bacterii periculoase. Asta au găsit comisarii ANPC la un singur restaurant fast-food al uneia dintre cele mai cunoscute companii din întreaga lume. Gheaţa plină de germeni ajungea în paharele cu...
Marti, 22.10.2019, 19:10
VIDEO - Are 720 de sexe, nu are creier şi se vindecă în două minute dacă e tăiată în două. O masă amorfă răstoarnă știința: ''Este o fiinţă vie care se numără printre misterele naturii''
Cel mai nou exponat de la Parc Zoologique de Paris, care va putea fi vizionat de public începând de sâmbătă, nu are gură, nici stomac sau ochi şi totuşi poate detecta hrana, pe care este capabil să o digere.
Joi, 17.10.2019, 23:56
Aceste trucuri îți vor salva sănătatea! Iată cum poți feri mâncarea de contaminarea cu bacterii
Alimentele pe care le consumăm sunt foarte importante în menținerea sănătății noastre, de aceea este foarte important ca acestea să fie protrejate de mediile care favorizează stricarea sau contaminarea acestora.
Luni, 14.10.2019, 15:23
Alertă în România! Geluri de duș retrase de pe piață, după ce s-au găsit bacterii care dăunează grav pielii
Un producător cunoscut de produse de îngrijire a retras de pe piața din România două sortimente de geluri de duș, după ce s-a descoperit că în compoziția acestora există bacterii ce pot provoca probleme grave ale pielii.
Miercuri, 02.10.2019, 16:31
Aproape și-a pierdut brațul, după ce o bacterie i-a mâncat carnea. Totul a pornit de la o simplă manichiură
O femeie a fost aproape de a-și pierde brațul după ce o bacterie pe care presupune că a luat-o de la un salon, i-a mâncat carnea de pe mână.
Luni, 23.09.2019, 11:50
Avem cei mai murdari bani! Leii româneşti transmit cele mai rezistente bacterii
Avem bani siguri, dar murdari. Leii româneşti transmit cele mai rezistente bacterii. Este rezultatul unui studiu realizat de doi cercetători străini premiaţi la gala IG Nobel, varianta trăznită a celebrelor premii Nobel
Sambata, 14.09.2019, 19:37
Ai procedat greșit! Cum se folosește capacul vasului de wc, de fapt
Atunci când folosim toaletă, toată lumea are în vedere cel mai important aspect: igiena! Totuși, puțini sunt cei care știu cum se folosește capacul vasului de wc, cu adevărat!
Luni, 19.08.2019, 18:49
Principala bacterie găsită pe scaunul copilului din mașina ta
Un nou studiu a dezvăluit cantitatea îngrozitoare de bacterii dăunătoare de pe scaunele de mașini pentru copii.
Joi, 15.08.2019, 23:15
Un medic a dezvăluit! Ce trebuie să faci înainte de duș ca să nu iei bacterii periculoase
Un medic a dezvăluit pe internet faptul că, de fiecare dată când dorește să se spele, el lasă dușul să meargă timp de câteva minute înainte de a intra în cadă. Motivul acestuia te va face să urmezi și tu acest obicei.
Joi, 18.07.2019, 17:39
Locuri din casa ta care ascund mucegaiuri și bacterii. La ce să fii atent
Faci curățenie săptămânal, aerisești locuința zilnic și nu lași niciodată vase nespălate în chiuveta de la bucătărie. Îți spui ca la tine acasă e foarte curat și nu există niciun pericol pentru sănătatea ta sau a familiei tale. Sunt, însă, câteva locuri și obiecte din casa ta cărora trebuie să le acorzi o atenție deosebită.
Vineri, 12.07.2019, 22:03
Apa sterilă din Maternitatea Giulești, plină cu bacterii!
Bacterii în apa sterilă şi angajaţi purtători ai stafilococului auriu! Este ceea ce au descoperit inspectorii sanitari în Maternitatea Giuleşti. Motivul ar fi unul banal, atrag atenţia chiar autorităţile: medicii, asistentele şi infirmierele...
Joi, 16.05.2019, 19:56
Rezultate devastatoare la maternitatea Giulești! Patru angajați sunt purtători ai stafilococului auriu
Apa sterilă folosită la matenitatea Giuleşti este contaminată cu bacterii, iar patru dintre angajaţi sunt purtători ai stafilococului auriu! Acestea sunt rezultatele anchetei făcute de inspectorii Direcţiei de Sănătate Publică
Joi, 16.05.2019, 16:30
Apa sterilă folosită la matenitatea Giuleşti, contaminată cu bacterii!
Apa sterilă folosită la matenitatea Giuleşti este contaminată cu bacterii, iar patru dintre angajaţi sunt purtători ai stafilococului auriu! Acestea sunt rezultatele anchetei făcute de inspectorii Direcţiei de Sănătate Publică, după ce în...
Joi, 16.05.2019, 16:17
Pacienți uciși de bacterii, la spitalul din Drobeta Turnu Severin
Bacteriile continuă să ucidă în spitalele româneşti. Doi pacienţi au murit la Spitalul din Drobeta Turnu Severin, iar pentru alţi doi se aşteaptă rezultatul analizelor. Între timp, Ministrul Sănătăţii continuă vizitele neanunţate în...
Luni, 06.05.2019, 19:41
Este oficial! Studiile dau peste cap masculinitatea bărbaților! Ce se ascunde sub barba provocatoare a domnilor
Un studiu realizat de Clinica Hirslanden din Elveția arată că bărbații cu barbă lungă poartă mai multe bacterii decât câinii.Studiul a fost demarat inițial pentru a determina existența unui risc pentru oameni de a contacta o boală transmisă de câini.
Joi, 18.04.2019, 15:13
Automatele de cafea, un focar de bacterii
Doi lei, o cafea şi o porţie de E-uri şi bacterii periculoase! Este avertismentul inspectorilor ANPC. În România, există aproape o sută de mii de automate de cafea, iar multe dintre ele nu respectă nicio regulă de igienă.
Joi, 14.03.2019, 19:24
Tragedia e mult mai mare în București! Sunt 13 morți până acum!
Acuzaţii extrem de grave la Institutul Marius Nasta din Capitală! În realitate, 13 oameni au murit din cauza bacteriilor, de la începutul anului, faţă de cinci cazuri raportate iniţial.
Vineri, 08.03.2019, 13:41
13 oameni au murit din cauza bacteriilor, la Institutul Marius Nasta din Capitală
Acuzaţii extrem de grave la Institutul Marius Nasta din Capitală! În realitate, 13 oameni au murit din cauza bacteriilor, de la începutul anului, faţă de cinci cazuri raportate iniţial. Mai grav este că medicul epidemiolog ştia de infecţii,...
Miercuri, 06.03.2019, 19:12
Carnea crudă, pericol pentru câini
Carnea crudă este cea mai la îndemână opţiune la care apelează adesea stăpânii de câini când vine vorba de hrăniea animalului de companie! Însă alegerea lor este mai periculoasă decât şi-au imaginat. O demonstrează oamenii de...
Miercuri, 06.03.2019, 16:59
Şapte din zece românce nasc prin cezariană şi astfel maternităţile nu vor scăpa niciodată de bacterii. Este explicaţia ministrului Sănătăţii
Şapte din zece românce nasc prin cezariană şi astfel maternităţile nu vor scăpa niciodată de bacterii. Este explicaţia ministrului Sănătăţii, care spune că doctorii fac operaţii fără o justificare medicală. Cu această teorie, Sorina...
Luni, 10.12.2018, 19:05
În România, pacienţi cu arsuri grave se luptă cu bacteriile înainte ca medicii să poată închide rănile
În România, pacienţi cu arsuri grave se luptă cu bacteriile înainte ca medicii să poată închide rănile. Un fost pompier din Constanţa ars într-o explozie a contractat şase bacterii intraspitaliceşti, cel mai probabil în mai puţin de 24...
Sambata, 17.11.2018, 19:30
Pompierul care a suferit arsuri grave, după un accident, a contractat nu mai puţin de şase bacterii
Purtat pe la trei spitale, apoi un verdict dur! Fostul pompier din Constanţa, internat cu arsuri grave la spitalul Floreasca, s-a ales cu şase bacterii nosocomiale! Vestea a picat ca un trăsnet peste familie. Mai ales că soţia sa ceruse, în urmă...
Sambata, 17.11.2018, 09:49
Sănătatea noastră este în pericol! ,,La robinet curg bacterii, apa nu este potabilă. Ministerul Sănătății recunoaște" Un deputat spune tot
Locuitorii din orașul Buftea se confruntă cu o mare problemă: apa furnizată de RAJA este nepotabilă, dovadă o fac rezultatele analizelor microbiologice.
Marti, 13.11.2018, 13:30
Istoria se repetă. Tânărul ars în explozia din Neamţ a ajuns cu bacterii periculoase într-un spital din străinătate
Tânărul ars în explozia unui bloc din Piatra Neamţ a fost operat în Belgia. Este stabil, dar medicii din Charleroi au identificat două bacterii pe care pacientul le-ar fi adus din România. Curăţarea rănilor a fost făcută de mântuială, a...
Marti, 06.11.2018, 19:09
Wow! De ce NU trebuie să acoperi NICIODATĂ vasul de toaletă cu hârtie igienică!
Mersul la toaletă când nu ești acasă nu este o experiență plăcută. Cei mai mulți evită să o facă, dar atunci când te cheamă natura, nu ai de ales. Una dintre cele mai des folosite metode de ”protecție” este acoperirea colacului cu hârtie igienică. Se pare că acest gest ne expune unui număr și mai mare de bacterii răufăcătoare!
Duminica, 28.10.2018, 18:03
Ne umplem de bacterii din cauza mizeriei din România. În unele magazine, angajaţii recunosc că nu prea spală galantarele în care ţin legumele
Legumele congelate ne pot îmbolnăvi şi dacă nu vin contaminate de la producător.
Luni, 09.07.2018, 22:04
Bucătarul unei grădiniţe din Capitală a băgat zeci de copii în spital. Pe mâinile lui s-au descoperit bacterii periculoase
Rezultat şocant al anchetei sanitare de la grădiniţa unde 29 de copii s-au intoxicat cu mâncare. Bucătarul a fost găsit vinovat. Avea pe mâini bacterii periculose, care au ajuns în farfuriile preşcolarilor. Poliţia s-a autosesizat şi a...
Vineri, 08.06.2018, 19:16
Românii habar nu au ce consumă! Carne periculoasă cu antibiotice, pe rafturile magazinelor
După gheaţa cu bacterii, românii au consumat şi carne cu antibiotice! Peste o tonă de oaie, porc şi viţel, toate tratate cu medicamente, au descoperit inspectorii în magazine.
Vineri, 18.05.2018, 14:14
Carne cu antibiotice în magazine. Legea interzice folosirea antibioticelor pentru a stimula creșterea animalelor
După gheaţa cu bacterii, românii au consumat şi carne cu antibiotice! Peste o tonă de oaie, porc şi viţel, toate tratate cu medicamente, au descoperit inspectorii în magazine.
Vineri, 18.05.2018, 13:32
Cuburi de gheață, retrase de la vânzare din cauza infestării cu bacterii periculoase
În perioada 7-11 Mai, comisarii ANPC au efectuat un control la operatorii economici care produc gheață alimentară.

ALERTĂ ÎN ROMÂNIA! BACTERII periculoase descoperite într-un produs folosit de milioane de oameni!
Clostridium şi bacterii coliforme au fost găsite găsite în gheaţa produsă de mai mulţi agenţi economici, relevă testele realizate de Centrul Naţional pentru Încercarea şi Expertizarea Produselor - Laborator Larex pe probe...
Luni, 14.05.2018, 18:13
Atenție! Apa îmbuteliată nu este întotdeauna bună de băut: Cum faci diferența și pe care o alegi
Apa îmbuteliată nu este întotdeauna bună de băut! Specialiştii au descoperit că unele mărci conţin germeni şi bacterii. Nici etichetele de pe sticlele cu apă nu sunt mai concludente.
Joi, 22.03.2018, 19:36
Apa îmbuteliată nu este întotdeauna bună de băut!
Apa îmbuteliată nu este întotdeauna bună de băut! Specialiştii au descoperit că unele mărci conţin germeni şi bacterii. Nici etichetele de pe sticlele cu apă nu sunt mai concludente.
Joi, 22.03.2018, 19:17
Afecțiunea pe care 8 din 10 persoane o au. Scapi foarte greu de această bacterie
O boală cu un debut discret și nedureros afectează tot mai mulți români. Opt din zece români suferă de parodontoză, o infecție la nivelul cavității bucale, cauzată de bacterii și tartru. Acesta este rezultatul unui studiu realizat de o clinică stomatologicădin Capitală. Partea proastă e că mulți nici nu știu de acest lucru.
Marti, 20.03.2018, 22:10